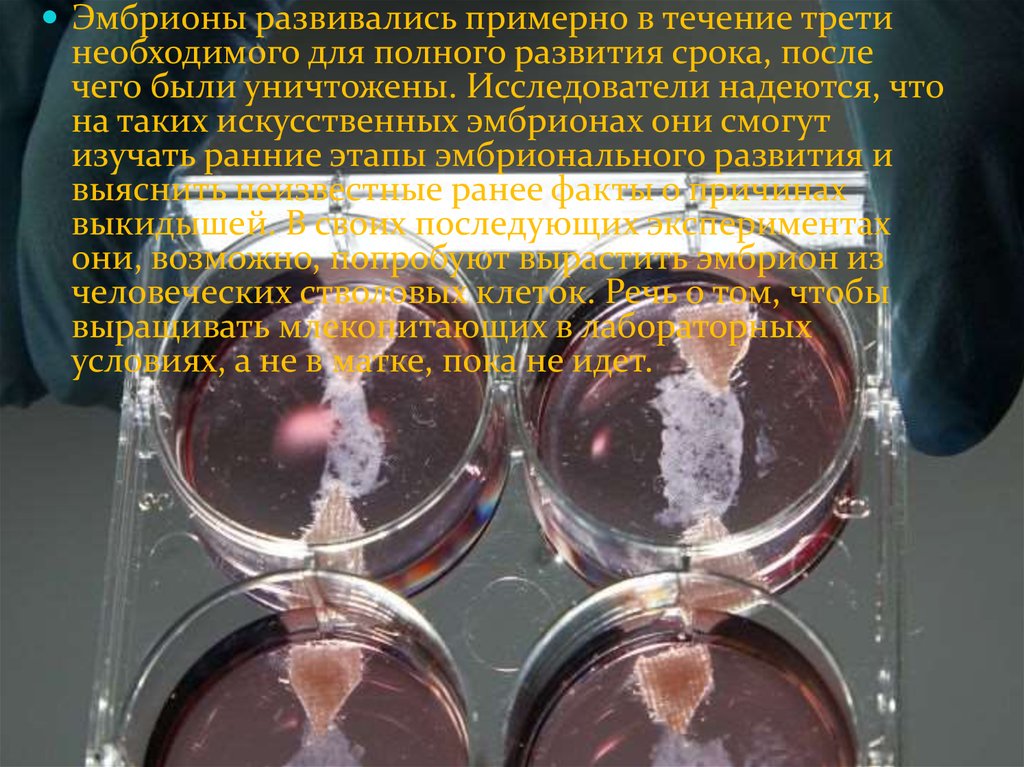

Похожие презентации:
Топ-5 самых удивительных достижений машинного обучения за 2018 год
1.
Студия МКОУПОРОТНИКОВСКАЯ СОШ
2.
3D-печать по металлуСамым первым устройством для создания 3D-прототипов
была американская SLA-установка, разработанная и
запатентованная Чарльзом Халлом в 1986 году и
использующая стереолитографию. Само собой, это еще не
был первый 3D-принтер в современном понимании, но
именно она определила, как работает 3D-принтер: объекты
наращиваются послойно. Халл сразу же создал фирму 3D
Systems, которая изготовила первое устройство объемной
печати под названием Stereolithography Apparatus. Первой
моделью этой машины, имевшей широкое распространение,
стала разработанная в 1988 году SLA-250. Понятное дело, что
и такой 3D принтер цветным не был, а работал лишь с
сырьём одного цвета, но для того времени и это было
сраднима с чудом.
3.
С течением времени развитие индустрии 3D-печати ускорялось, появлялись новые фирмы
производители 3D-принтеров, вносящие свой
вклад в ее разработку, использовались новые
материалы и принципы, размеры и цены
устройств становились все меньше – первые 3Dпринтеры были огромны, сейчас же они
умещаются на столе (исключая разве что
промышленный 3D-принтер). Современный
трехмерный принтер все больше становится
похож на обычный, печатающий на бумаге, по
внешнему виду и технологии нанесения
«красящего» вещества. Печатаемые им модели
отличаются еще и высокой прочностью, поэтому
могут применяться в качестве готовых изделий.
4.
Что можно сделать, если появилось желание попробовать3D-печать металлом в домашних условиях? Для печати
металлом необходимы чрезвычайно высокие
температуры, вряд ли вы сможете использовать обычный
FDM 3D-принтер для этого, по крайней мере пока.
Ситуация может измениться через несколько лет, но
сейчас домашней 3D-технике это недоступно. Если вы
хотите сделать выглядящие металлическими распечатки у
себя дома, лучший вариант — использование пластика
содержащего частицы металла.
5.
Эти филаменты содержат значительныйпроцент металлических порошков, но и
достаточно пластика — для печати при
низкой температуре любым 3D-принтером. В
то же время, они содержат достаточное
количество металла, чтобы соответственно
выглядеть, ощущаться и иметь вес близкий к
весу металлического предмета.
Изделия из филамента содержащего железо
даже покрываются ржавчиной в
определенных условиях, что добавляет
правдоподобности, а вот проржаветь насквозь
и испортиться от этого не смогут — и в этом
их преимущество перед настоящими
металлическими предметами.
6.
7.
Искусственные эмбрионыНовейшее изобретение британских ученых
практически перевернуло представление о том, как
была создана жизнь. Исследователи смогли вырастить,
используя только стволовые клетки, мышиный
эмбрион. При этом, что особо примечательно, не
произошло традиционное оплодотворение
яйцеклетки. Тем не менее ученые признали: этот
эмбрион на текущем этапе развития науки не имеет ни
одного шанса стать настоящей мышью, но, все-таки,
начало таких исследований положено. И подобные
эксперименты вполне могут иметь большое будущее. В
ближайших планах исследователей – создание
искусственного человеческого эмбриона. Если такое
произойдет, то ученые получат уникальную
возможность для экспериментальных исследований и
редактирования генома.
8.
Магдалена Зерничка-Гетц (Magdalena Zernicka-Goetz)и ее коллеги поясняют, что все более ранние попытки
создания искусственных эмбрионов проваливались.
Ученые использовали клетки лишь одного типа –
эмбриональные стволовые, которых оказывалось
недостаточно для полноценного развития эмбриона.
Исследователи же их Кембриджа решили
воспользоваться не только эмбриональными, но и
трофобластными стволовыми клетками, которые в
дальнейшем культивировались в трехмерной гелевой
матрице.
9.
Эмбрионы развивались примерно в течение третинеобходимого для полного развития срока, после
чего были уничтожены. Исследователи надеются, что
на таких искусственных эмбрионах они смогут
изучать ранние этапы эмбрионального развития и
выяснить неизвестные ранее факты о причинах
выкидышей. В своих последующих экспериментах
они, возможно, попробуют вырастить эмбрион из
человеческих стволовых клеток. Речь о том, чтобы
выращивать млекопитающих в лабораторных
условиях, а не в матке, пока не идет.
10.
Безопасная квантовая связьКитай уже давно и успешно экспериментирует
в области квантовой связи. При подготовке
военного парада в 2009 году в честь 60-летия
основания КНР для обеспечения безопасности
уже использовалась каналы связи на основе
этой технологии. А первым банком в мире,
использующим квантовую связь, стал
Промышленно-торговый банк Китая в 2015
году.
11.
вот китайский прорыв – для демонстрацииреальных возможностей новой технологии Бай
Чуньли, руководитель Китайской академии наук,
совершил «квантовый» звонок из Пекина и
поздравил своих коллег с успешным запуском
оптоволоконной квантовой линии. Для первого в
мире межконтинентального «квантового
видеозвонка» был дополнительно использован,
запущенный в прошлом году, китайский спутник
квантовой связи Micius («Мо-Цзы»).
12.
Новые китайские технологии позволилизначительно увеличить эффективное
расстояние квантовой связи. Для создания
всемирной сети безопасного обмена
информацией, которая впоследствии может
вытеснить все существующие типы связи,
Китай будет сотрудничать со многими
странами. По оценкам экспертов уже через 1015 лет стоимость дорогой квантовой связи
может значительно уменьшится, что и
обеспечит ей быстрое распространение по
планете.
13.
нейронные сетиБританская компания DeepMind, в 2014 году ставшая
частью Google, постоянно работает над
совершенствованием искусственного интеллекта. В июне
2018 года ее сотрудники представили нейронную сеть,
способную создавать трехмерные изображения на основе
двумерных. В октябре разработчики пошли дальше —
они создали нейросеть BigGAN для генерации
изображений природы, животных и предметов, которые
сложно отличить. Как и в других проектах по созданию
искусственных изображений, данная технология
основана на генеративно-состязательной нейросети.
Напомним, что она состоит из двух частей: генератора и
дискриминатора. Первая создает изображения, а вторая
оценивает их схожесть с образцами идеального
результата.
14.
В сентябре исследователи из УниверситетаКарнеги-Мелона при помощи генеративносостязательных нейросетей создали систему
для наложения мимики одних людей на лица
других.
15.
Солнечныебатареи
Отцом солнечных батарей является
Александр Эдмонд Беккерель. Именно он
открыл базовый принцип –
фотогальванический эффект. Этот термин
означает трансформацию энергии Солнца в
электричество. Но стоит помнить и о
величайшем физике Архимеде, которого
можно назвать прапрадедушкой открытия.
16.
Отношение к альтернативным источникам энергии внашей стране постепенно начинает меняться. Еще
несколько лет назад это воспринималось как причуда,
теперь, все большее количество людей начинают
собирать информацию о том, как можно сэкономить на
счетах за коммунальные услуги. Одно из интересных
направлений — уличное освещение на солнечных
батареях. Можно ли на этом деле сэкономить, сказать
сложно — зависит от многих факторов. Но сделать
освещение от солнечной энергии можно.
Фотоэлектрическая солнечная батарея имеет
практически неограниченный срок службы (за 25-30
лет их выработка снижается на 10-20%). Она не шумит,
не требует топлива, не пахнет, не надо таскать
канистры, менять масло и строить отдельное
помещение, имеющее шумоизолирующие стены,
вытяжную вентиляцию и выхлопную трубу.
17.
Одна солнечная батарея мощностью 80-100Вт обеспечивает необходимое освещение,
работу небольшого телевизора, водяного
насоса, триммера. А с установкой и
подключением справится любой учившийся
в школе. В солнечных батареях нет
«механики» (по сути, нечему ломаться),
применено закалённое, текстурированное
стекло, которое не отражает лучи, позволяет
собрать больше на 15 % рассеянного
излучения, и выдерживает любой град и
ветер.

Электроника
Электроника








